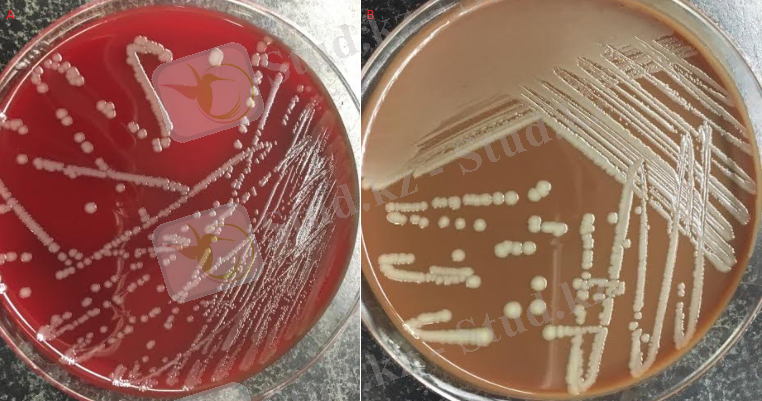
http://pubs.sciepub.com/portal/downloads?doi=10.12691/ajmcr-5-8-7&filename=fig2.png
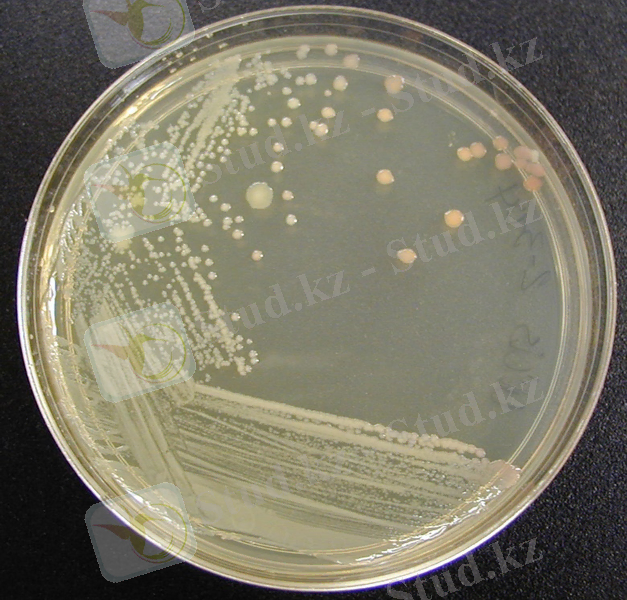
http://faculty.collin.edu/mweis/Microbiology/Lab/Lab%20Exercises/colony_characteristics/photos_drw/micro_cultural_char_agar.jpg

Арқалық қаласының Құс фабрикасында пастереллезге қарсы ветеринариялық-санитариялық іс-шараларды ұйымдастыру


НОРМАТИВТІК СІЛТЕМЕЛЕР
Дипломдық жұмыста келесі нормативтік сілтемелер қолданылды:
- Мемлекеттік стандарт 12. 1. 003
- Мемлекеттік стандарт 12. 1. 004
- Мемлекеттік стандарт 12. 1. 010
- Мемлекеттік стандарт 12. 1. 041
- ҚНжЕ 2. 01. 02-85
- ОНТП 24-86
- ППБ-01-03
- Мемлекеттік стандарт 12. 4. 026
- 2015 жылғы 29 мамырдағы №498 ҚР АШМ-нің жануарларды өсіруді, өткізуді жүзеге асыратын өндіріс объектілеріне қойылатын ветеринариялық талаптары
- Ветеринариялық (ветеринариялық-санитариялық) қағидаларды бекіту туралы Қазақстан Республикасы Ауыл шаруашылығы министрінің 2015 жылғы 29 маусымдағы № 7-1/587 бұйрығы
- Жануарлар мен құстардың пастереллездерін зертханалық диагностикалау бойынша әдістемелік нұсқаулар
АНЫҚТАМАЛАР
Құстардың пастереллезі (тырысқақ) - құстардың пастереллалардан туындаған жұқпалы ауруы және серозды және шырышты қабықтарда көптеген қан кетулер пайда бола отырып, септицемия симптомдарының жедел өтуінде көрінеді.
Құс фабрикасы - өнеркәсіптік негізде Құс шаруашылығы өнімдерін өндіретін кәсіпорын.
Санитарлық-профилактикалық іс-шаралар (син. профилактикалық іс - шаралар) - жұқпалы аурулардың алдын алуға бағытталған тұрақты жүргізілетін санитариялық-гигиеналық, емдеу-профилактикалық, ветеринариялық-санитариялық, коммуналдық және әкімшілік шаралар жүйесі.
Қоректік орта - бұл микроорганизмдерді жасанды, зертханалық жағдайда өсіруге арналған заттардың қоспасы.
Жұқпалы аурулар - организмге патогенді (ауру тудыратын) микроорганизмдердің, вирустар мен приондардың енуінен туындаған аурулар тобы.
Микроорганизмдердің патогендігі (грек. pathos азап, ауру + gennao жасау, өндіру; sin. патогенділік) - микроорганизмдердің қабылдаушы организмнің тіндерінде тамыр алу, оларда көбею қабілеті, патологиялық өзгерістер тудырады.
Вируленттілік (лат. virulentus улы) - табиғи немесе жасанды жұқтырудың стандартты жағдайларында белгілі бір түрдегі жануарларға қатысты инфекциялық агенттің осы штаммының патогенділік дәрежесі.
Эпизоотология (эпизоотия және грек. lógos-ілім) - эпизоотиялық процестің заңдылықтарын, яғни жануарлардың жұқпалы ауруларының пайда болуы мен таралуының себептері мен жағдайларын зерттейтін және олардың алдын-алу және бақылау әдістерін жасайтын ғылым.
Антиген - организм бөтен немесе ықтимал қауіпті деп санайтын және организм әдетте өз антиденелерін (иммундық жауап) шығара бастайтын кез-келген зат.
Коагуляция (лат. coagulatio-коагуляция, қоюлану) және флокуляция (лат. flocculi - сынықтар, қабыршақтар) -коагуляциялық құрылымдар түзе отырып, ілінісу күштерінің әсерінен дисперсті жүйелердің ұсақ бөлшектерінің үлкен агрегаттарға жабысуының физикалық-химиялық процестері.
БЕЛГІЛЕУЛЕР МЕН ҚЫСҚАРТУЛАР
- МемСТ - мемлекеттік стандарттар;
- ҚНж/Е - құрылыс нормалары және ережелері;
- ҚР -Қазақстан Республикасы;
- АШМ - ауыл шаруашылығы министрлігі;
- ЕПА - ет пептонды агар;
- ЕПС - ет пептонды сорпа;
- рН - сутек тотығы;
КІРІСПЕ
Ғылымның өзегі болып табылатын жалпы эпизоотологияның алдында қазіргі заманғы мал шаруашылығын ұйымдастыру жағдайында жұқпалы аурудың қоздырғышының таралу ерекшеліктерін зерттеп, эпизоотикалық процестің ерекше белгілері мен заңдылықтарын анықтау міндеті тұр. Жұқпалы аурулардың пайда болуын болдырмау үшін эпизоотиялық процестің жеке буындарын білу керек, оны дұрыс алу, әр түрлі факторлардың жануарлар ағзасына тигізетін кері әсерін бағалау, оны уақытында өткізу, ең соңғы пайдалану ғылымның жетістіктері мен озық тәжірибе [1] . Жұқпалы ауруларға қарсы терапия эпизоотияға қарсы шаралар жүйесінің ажырамас бөлігі болып табылады. Оның міндеті - аурудың себептерін жою және жануарлардың өнімділігін қалпына келтіру. Медициналық көмек көрсету туралы мәселені шешкен кезде жануардың нақты ауруы мен экономикалық құндылығын ескере отырып, экономикалық негізділікті ескеру қажет. Емдеудің сәттілігі уақытылы диагноз қоюға, дәрі-дәрмектерді дұрыс таңдауға, оны қолдану тәсілдеріне және уақытына байланысты. Республиканың құс шаруашылығына айтарлықтай экономикалық зиян келтіретін респираторлық аурулардың бірі - құс пастереллезі болып табылады. Экономиканы жұқпалы аурулардың енуінен қорғауға ерекше назар аудару қажет. Уақытында дезинфекция, дератизация және профилактикалық вакцинация жүргізу керек, жануарларды ұстау мен азықтандырудың ветеринариялық-санитарлық ережелерін сақтау қажет [2] . Бүгінгі таңда құс шаруашылығында жұқпалы аурулар да үлкен қауіп төндіреді, оның таралуына шектеулі аудандарда құстардың едәуір шоғырлануы, шаруашылық ішілік және шаруашылық аралық қатынастар, құс өсіру жөніндегі ережелерді әртүрлі бұзушылықтар ықпал етеді. Құсты табиғи қорғаныстың көптеген көздерінен (инсоляция, қозғалу және т. б. ) айыратын интенсивті ұстау әдістері оның денесінің спецификалық емес қарсыласуының төмендеуіне бейімдетеді. Өндірістік негізде құстарды жаңа жағдайда өсіру кезінде олардың жанасуы күшейеді, нәтижесінде қайта жұқтыру мүмкіндігі артады.
Дипломдық жұмыстың мақсаты: Арқалық қаласының «Құс фабрикасында» пастереллезге қарсы ветеринариялық-санитарлық іс-шараларды ұйымдастыру болып табылады.
Осы мақсатқа жету үшін келесідей міндеттер қойылды:
- Арқалық қалсының «Құс фабрикасының» пастереллезге қатысты соңғы 5 жылғы індеттік жағдайын талдау;
- Құс фабрикасында құстардың саны мен туу көрсеткіштерін талдау;
- Құс фабрикасындағы ветеринариялық-санитарлық режимнің сәйкестігін талдап, акті құрастыру
- Пастереллезге мониторингтік жүйе негізінде зертханалық зерттеулер жүргізу;
- Құс фабрикасында пастереллезді болашақта болдырмау мақсатында іс-шараларды ұйымдастыру жоспарын құру;
1 НЕГІЗГІ БӨЛІМ
1. 1. Әдебиетке шолу
- Құс пастереллезі туралы қысқаша сипаттама және тарихи анықтамасы
Құстардың пастереллезі (Пастереллез, геморрагиялық септицемия, құстардың тырысқақ ауруы) - барлық типтегі және барлық жастағы құстарға әсер ететін, септицемия құбылыстарымен, қабыну геморрагиялық диатезімен және жоғары өліммен сипатталатын инфекциялық жұқпалы ауру. Холера ауру және ауру құстардан, ауру, күтім, тамақ, су және қызмет көрсететін персоналдан тарайды. Ауру Францияда 1782 жылы «құс тырысқақтары» деген атпен зерттеле бастады, бұл туралы 1831 жылы ғылыми әдебиеттерде сипатталды. Тауық холерасының қоздырғышын алғаш рет Э. М. Семмер мен Л. Пастер 1878-1880 жж Осы жылдары Пастер бактериялардың дақылдарын әлсірету бойынша алғашқы тәжірибелерді жүргізіп, құстарға иммунизация жүргізді. 1910 жылы оның микробиологиядағы еңбегінің құрметіне бұл қоздырғыш Пастерелла деп аталды, ал оны қоздыратын ауру - пастереллез. Ұзақ уақыт бойы ғылым пастерелла классификациясына зоологиялық тұрғыдан қарады және құстардың әр түрінде ауру микробтың дербес түрінен болады деп есептелді. Тек 1939 жылы Розенбуш пен Мергант бұл көзқарастың сәйкес еместігін дәлелдеді және аурудың қоздырғышын тәуелсіз түр ретінде сипаттады - Pasteurella multocida [3] . П. В. Сизов, В. П. Шаматава, М. К. Ганиев, Н. М. Никифорова, А. В. Лукьянченко, А. Н. Борисенкова және басқалар ауруды зерттеуге және нақты емдеу әдістерін жасауға үлкен үлес қосты. 1979 жылы пастереллез лейкоздан, туберкулезден, бруцеллезден кейін аз қауіпті, бірақ ірі қара мал арасында кең таралған жұқпалы ауру ретінде тізімге енгізілді. В тізіміндегі аурулар-әлеуметтік-экономикалық және санитарлық тұрғыдан қауіпті деп саналатын жұқпалы аурулар. Жануарлар мен мал шаруашылығы өнімдерінің халықаралық саудасы кезінде осы инфекциялардың қоздырғыштарының таралуы өте қолайсыз салдарға әкелуі мүмкін [4] . Пастереллез әлемнің барлық елдерінде кең таралған. Ірі қара малдың пастереллезі бойынша ең қолайсыз аймақтарға Еуропаның оңтүстік бөлігі, Африка континенті, Орта Шығыс, Оңтүстік және Оңтүстік-Шығыс Азия жатады. Бірнеше ондаған жылдар бойы көптеген бағыттарда жүргізілген қарқынды зерттеулер қолданыстағы идеяны түбегейлі өзгертті және ауылшаруашылық жануарларының пастереллездері туралы білімдерін едәуір кеңейтті. Пастереллез әлемнің барлық елдерінде кең таралған. Ауру жедел, сирек субакуталы және созылмалы. Республикалық ветеринариялық зертхананың деректері бойынша ауыл шаруашылығы жануарлары арасындағы пастереллез ареалы Қазақстанның барлық облыстарын қамтиды, бірақ қолайсыздық дәрежесі кең шекте ауытқиды. Батыс Қазақстан, Алматы, Шығыс Қазақстан облыстары жылқылардың пастереллезбен ауыруы бойынша неғұрлым қолайсыз болып табылады; Қостанай, Батыс Қазақстан, Ақтөбе облыстары-ірі қара мал басы; Алматы, Батыс Қазақстан, Қарағанды облыстары -шошқалар; құстар-Батыс Қазақстан, Алматы және Солтүстік Қазақстан облыстары [5] . В. Дернованың Қазақстан Республикасының аумағында пастереллаларды зерттеу бойынша жүргізген зерттеулері жылқы, ірі қара мал, ұсақ қара мал, шошқа, құс және басқа жануарлар арасында пастереллездің таралғанын айғақтайды, бұл ретте ірі қара малдың пастереллезі Қостанай, Батыс Қазақстан, Ақтөбе, Алматы облыстарында жиі кездеседі. Бұл инфекцияның таралуында синантропты кеміргіштер маңызды рөл атқарады, өйткені пастереллез қатаң анықталған аумақтарға тұрақты түрде сәйкес келеді. Торғай, Ақтөбе және Батыс Қазақстан облыстарында киіктердің жаппай қырылуын зерттеу кезінде пастереллезді инфекция жағдайлары сипатталған. Қоздырғыш тек өлген киіктердің мүшелерінен ғана емес, сонымен бірге құлаған кеміргіштер мен жыртқыштардан да оқшауланған [6, 7, 8] . Жедел дамыған кезде, айдары мен қауырсын ұштарының цианозы, крупозды плевропневмония байқалады; органдарда, әсіресе эпикард пен эндокардтың астында көптеген қан кетулермен жүретін геморрагиялық диатез (жүрек қанмен шашылған сияқты) ; серозды фибринозды перикардит; бауыр мен миокардтағы түйіршікті деградация және ошақты некроз; жедел катаральды немесе геморрагиялық дуоденит (қабырғалары қалыңдаған, гиперемияланған, қан кетулермен, мазмұны қанмен) ; көкбауыр кейбір жағдайларда үлкейеді [9, 10] . Ауру құс депрессияға ұшырайды, ұйқышыл болады; ашық тұмсықтан көбінесе қанмен араласқан тұтқыр шырыш ағады. Тән ерекшелігі - қан қоспасы бар жасыл сұйықтықтың бөлінуі. Жануарлардың дене температурасы 43 С дейін. Аурудың ұзақтығы бірнеше сағаттан 3-4 күнге дейін. Нәтижесі өлімге әкеледі, дәрі-дәрмектерді қолданғанда ауру созылмалы түрге ауысады. Субакуталық курс жедел белгілермен қатар жүреді, бірақ онша айқын емес. Аурудың ұзақтығы 5-10 күнге дейін. Созылмалы түрінде өлген құстардың мәйіті жүдеу, жоталары қою көк. Зақымдалған сақал мен жүн 2 - 3 есе үлкейген, ісінген, шырынды, жапырақтары арасында желатинді сарғыш экссудат. Егер ауру ұзаққа созылатын болса, онда сақал мен жүн тығыз, деформацияланған, некротикалық аймақтары бар; кесілген кезде коагуляцияланған ақуызға ұқсас үлпектер қоспасы бар лас сұйықтық немесе ақшыл-сұр түсті бұйра массасы сыртқа шығады. Анемиялық шырышты қабаттар, бастың тері асты тінінің ісінуі байқалады. Көздері мен тыныс алу жолдары зақымдалған құстарда көздің айналасындағы және мұрын саңылауларының кептірілген экссудат қыртыстары, инфраорбитальды синустарда сарғыш казеозды массалар, конъюнктиваның, мұрын қуысының шырышты қабаттарының қызаруы анықталады. Мұрын қуысында шырышты немесе серозды-іріңді экссудаттың едәуір мөлшері кездеседі. Осындай өзгерістер көмейде, трахеяда, тіпті өкпеде де байқалады (катаральды бронхопневмония) . Зақымдалған буындар ісінген, үлкейген, деформацияланған, артикулалық қуыстарда фибринозды-некротикалық казеозды массалар бар. Жүректе және серозды түйіндерде, көбінесе ішектің шырышты қабатында қан кетулер бар, ауыр геморрагиялық энтерит, әсіресе он екі елі ішекте; бауырдағы некротикалық ошақтар. Кейбір жағдайларда патологиялық өзгерістер тек ішекте болуы мүмкін (энтерит) . Жоғарғы тыныс жолдарының және ауа қапшықтарының зақымдануы бар. Олардың қабырғалары қалыңдаған, мөлдір емес, фибрин пленкаларымен жабылған. Ауа қапшықтары серозды экссудатпен толтырылған. Көкбауыр кейде үлкейген, қою қызыл, ақшыл, кейде некроздың ақшыл-сарғыш-сұрғылт ошақтары болады. Созылмалы пастереллез дербес түрде де, басқа бактериялық инфекциялармен бірге (көбінесе колибакиллозбен немесе листериозбен бірге) пайда болуы мүмкін [11, 12, 13, 14] .
1. 1. 2 Құс пастереллезінің қоздырғышы және оның сипаттамалар
Патшалығы: Procariota
Бөлім: Firmicutes.
Секция: 5
Отбасы: Pasteurellaceae
Тұқымы: Pasteurella (6 түрден тұрады)
Түрі: Pasteurella multocida
Қан мен ағзалардағы жағындылардағы P. multocida қозғалмайтын, қысқа, сопақ немесе жұмыртқа тәрізді бактериялар, олар эндоспора түзбейді. Ұзындығы 0, 4 . . . 1, 2 мкм, ені 0, 3 . . . 0, 4 мкм. Өсінділерден шыққан жағындыларда Пастерелла коккоидты таяқшаларға ұқсайды, олар жеке, жұпта, қысқа тізбек түрінде орналасады, спора түзбейді, шырышты капсула түзеді. Полиморфизмге ие. Пенициллин мен стрептомициннің суббактерицидтік дозалары болған кезде, пастерелла биполярлы бояу қабілетін жоғалтатын салыстырмалы түрде үлкен таяқшалар түрінде өседі. Пастерелла негізгі анилин бояғыштарының барлық ерітінділерімен жақсы боялады, олар грамтеріс. Бұл микробтың тән ерекшелігі - қаннан немесе құстардың органдарынан, сондай-ақ жартылай сұйық ортадағы жаңа оқшауланған дақылдардан алынған анилинді бояулармен биполярлы бояу. Пастерелланың биполярлығы Лефлер метилен көгімен, карболфучсинмен боялғанда айқын көрінеді. Пастерелланың капсула нұсқаларындағы капсуланы сафраниннің су ерітіндісімен қыздыру арқылы бояу арқылы анықтауға болады (Олт әдісі) . Бірақ бұл Burri-ге сәйкес бояуды Rebirga әдісіне сәйкес қосымша бояумен жасау кезінде айқын көрінеді [15, 16] . Pasteurella multocida - факультативті анаэроб, оның тіршілік әрекетінің температурасы 22-42 ° C, оңтайлы температура 37-38 ° C. Ортаның оңтайлы рН мәні 7, 2-7, 4 құрайды. Олар әдеттегі қоректік орталарда өседі - ЕПА және ЕПС, бірақ егер оларға қан сарысуы қосылса, Hottinger немесе Martin орталарында жақсы өседі [17] .

Сурет 1. Пастереллалардың ет пептонды сорпада өсуі
Өсудің бірінші күні ЕПС бұлыңғыр болып, лайлануы біркелкі болады. Пробирканың түбінде былжырлы шөгінді пайда болады, ол шайқалғанда иіріліп көтеріледі (муар толқындары секілді) . Содан кейін лайлылық біршама жоғарылайды, ал 4-8 күндік өсуден кейін пробиркадағы сорпа ағарады, төменгі жағында айқын былжырлы шөгінді пайда болады. Қабықша мен қабырға сақинасы, әдетте, қалыптаспайды (сурет 1) . Пастерелла қарапайым қоректік орталарға қарағанда Мартин мен Хотнатова орталарында қарқынды өседі. M- және R формалары бар. М-формалары қарқынды түрде өсіп, айқынырақ шламды шөгінді береді. R-формалары фулкулентті немесе түйіршікті тұнба түзеді (сурет 2) [18] .
Сурет 2. Пастереллалардың Мартин мен Хотнатова орталарында өсуі
S тәрізді формалар ет пептонды агарда ұсақ, дөңес, мөлдір, дөңгеленген сұр колониялар түрінде түзіледі. Олар капсула түзілуіне байланысты қиғаш өтетін жарықта флуоресценцияланады және вируленттілігі жоғары. М-формалары - мөлдір емес ортасы бар, ақшыл-ақ түсті, шеттері тегіс, капсуласы орташа, вирулентті шырышты консистенция; R-формалары - мөлдір емес мөлдір емес колониялар, капсула жоқ, авирулентті (сурет 3) [19] .
Сурет 3. Ет пептонды агарда пастереллалардың өсуі
Пастерелланың тұрақтылығы салыстырмалы түрде төмен - көңде, жерде және шіріген мәйіттерде пастерелла 1-ден 3 айға дейін өміршең болып қалады. Мұздатылған күйде сақталған тауықтар мен үйректердің өлекселерінде пастерелла бір жыл бойы өміршең болып қалады. 70-90 ° C температурада олар 5-10 минут ішінде, 1-5 ° C температурада - бірнеше күн ішінде өледі. Пастерелла ашық ауада және күнде кептірілген кезде 48 сағат ішінде, тікелей күн сәулесінің әсерінен 10 минут ішінде өледі. Ауру жұқтырған объектілерде - 35 минуттан 34 күнге дейін, құстардың қоқысында - 12-ден 22-72 күнге дейін. Дезинфекциялаушы заттардан пастерелла деструктивті әсерге ие - оларды 1 минут ішінде өлтіретін карбол қышқылының 5% ерітіндісі, әк сүтінің 5% ерітіндісі - 4-5 минуттан кейін, ағартқыштың 1% ерітіндісі - 10 минуттан кейін. 2% натрий гидроксиді ерітінділері және 3-5% ыстық креолин ерітінділері пастереллаға зиянды әсер етеді [17, 18, 19] . Пастерелланың патогенді және вирулентті қасиеттері әр түрлі және олар құстардан оқшауланған кезде айқын көрінеді. Эпизоотиялық штамдар ақ тышқандар мен қояндар үшін өте қауіпті. Вируленттілік, капсула және токсин түзілуі арасында корреляция анықталды. Жаңа оқшауланған дақылдардың вируленттілігі жоғары. Зертханалық жағдайда дақылдарды сақтау кезінде пастерелланың вируленттілігі күрт төмендейді. Аурудың өткір кезеңінде Пастерелла тез көбейеді, қан айналым және лимфа жүйелеріне еніп, септицемия тудырады. Эндотоксиндер мен басқа агрессивті заттардың пайда болуына байланысты тамырлардың қабырғалары зақымдалады, олар плазма, жасушалық элементтер үшін өткізгіш болады, геморрагиялық диатез дамиды, тері асты және бұлшықет тіндерінің ісінуі пайда болады. Қан айналымының бұзылуы нәтижесінде тіндердің некрозы пайда болады. Пастерелла муитоцида - белсенділігі төмен бактериялар. Мартендік сорпада индол түзеді, каталазға реакциясы оң, глюкозаны, сахарозаны, бекондарды, сорбитті ашытады, лактоза, мальтоза, арабиноза, дульцит, рафиноз, салицин, рамноз, декстринге белсенді емес. Желатинді жұқармайды. Қоздырғыш нитраттарды нитриттерге дейін төмендетеді. Пастерелла дақылында күкіртті сутек түзілмейді немесе аз мөлшерде түзіледі [20, 21, 22] . Сүт коагуляцияланбайды, қан агарына гемолиз туғызбайды, сиырдың өтінде өспейді және онда ериді. Бұл қасиет Пастерелланы колитифозды бактерияларынан ажырату үшін қолданылады. Пастереллез қоздырғыштары көптеген антигендердің болуымен сипатталады. Жасуша компоненттерінің антигендік қасиеттері бар: липополисахаридтер кешені, бос эндотоксин, полисахарид. Негізгі антигендер - пастерелла тұқымдасы үшін кең таралған соматикалық ыстыққа төзімді қорғаныс және жылу-лабильді спецификалық капсулалық полисахарид, оларға байланысты Пастерелла бірнеше топқа бөлінеді. Pasteurella multocida төрт капсула типтері A, B, D және E деп белгіленеді. Серовар соматикалық немесе O түрін көрсететін араб цифрына сәйкес келеді. Соматикалық антигендерді анықтаудың қолданыстағы жүйелерінің ешқайсысы мамандарды толығымен қанағаттандырмайды, әсіресе эндотоксинмен байланысты антигендік детерминанттардың саны мен түрлеріне қатысты [23] . Пастерелла multocida 16-дан астам серовардан тұрады, олардың кейбіреулері жануарлар мен құстардың белгілі бір түрлерімен және ауру белгілерімен байланысты. Сероварлар А: 1 және А: 3 - құстарда пастереллез қоздырғышы. Pasteurella multocida антигендерінің табиғаты толық зерттелмеген. Капсула затымен байланысты негізгі компоненттер туралы қазіргі түсінікті қысқаша сипаттауға болады:
1) β-антиген - типке тән полисахарид, жанама гемагглютинация реакциясы кезінде эритроциттерге адсорбцияланады; флуоресцентті және мукоидты нұсқаларды шығаратын микроорганизмдерде пайда болады;
2) d-комплексі - полисахарид-ақуыз, жасуша қабырғасына тығыз бекітілген, иммуногенді, шамалы лабильді;
3) γ-антиген - барлық нұсқадағы микроорганизмдерде кездесетін липополисахарид, жасуша қабырғасын құрайды; әрқайсысында әр түрлі О- немесе соматикалық сероварларға жауап беретін бір немесе бірнеше антигендік детерминанттар бар. Пастерелла морфологиясы, цитологиясы, биохимиясы, физиологиясы бойынша зерттеулер көп және екіұшты екенін атап өткен жөн. Болашақта микроорганизмнің иммуногендік және физико-биохимиялық сипаттамаларын кешенді түрде зерттеген жөн, өйткені бұл тәсіл вакцинаның қан сарысуының препараттарын құру кезінде маңызды болатын in vitro өсіруді бағалау критерийлерін анықтауға мүмкіндік береді [24, 25, 26] .
1. 1. 3 Құс пастереллезінің патогенезі мен клиникалық белгілері
Табиғи жағдайда пастерелла жануарлардың ағзасына тыныс алу жолдары мен алиментарлы жолдармен, ал теріні бұзу арқылы жиі енеді. Интродукция кезінде Пастерелла көбейіп, лимфа мен қанға еніп, септицемияға ұшырайды және жануарлардың өліміне көп жағдайда 12 - 36 сағаттан кейін капиллярларға үлкен зақым келтіреді. Нәтижесінде тері асты мен бұлшықет тінінде және геморрагиялық диатезде кең көлемді ісіну дамиды. Септицемия неғұрлым тез жүрсе, қоздырғыш соғұрлым вирулентті болады. Септицемия ауруға төзімді жануарларда және әлсіз вирулентті пастерелла ағзаға түскенде дамымайды. Олардың ауруы қоздырғышты жеке органдарда, көбінесе өкпеде крупозды немесе катаральды-іріңді қабыну дамып, оқшаулауымен субакуталық немесе созылмалы ағымын алады. Гиперакуталы және өткір ағыммен крупозды пневмония дамуға үлгермейді, өкпеде тек ісіну мен гиперемия құбылыстары кездеседі. Құстарда пастереллез өткір және перманентті ағымда өтеді.
Өткір түрі: әлсіреу, құстың жартылай ұйықтау күйіайдары мен жотаның айқын цианозы; температураның 43 ° C дейін тез көтерілуі; ұсынылатын тағамнан бас тарту және қатты шөлдеу; сары сұйықтық тұмсығынан босату; шырышты немесе қанмен араласқан диарея түріндегі ішектің бұзылуы; кейбір жағдайларда құстың өлімі аурудың белгілерінсіз болуы мүмкін; мұрыннан шырышты, көбікті бөлінділер. Аурудың перманентті ағымы : буындардың зақымдануынан қанаттар мен аяқтарда өсінділердің пайда болуы; тыныс алу белгілері: ысқырықты сырылдар, мұрыннан су ағу, тыныс алудың жиі қиындауы; көздің қабынуы. Бұл симптом сирек кездеседі; дененің осы бөліктерінің көлемінің ұлғаюы ретінде сыртқы көрінетін табанының аймағында, айдарындағы және сырғалардағы ісіктер; тәбеттің төмендеуі [27, 28, 29] .
1. 1. 4 Құс пастереллезінің диагностикасы
... жалғасы- Іс жүргізу
- Автоматтандыру, Техника
- Алғашқы әскери дайындық
- Астрономия
- Ауыл шаруашылығы
- Банк ісі
- Бизнесті бағалау
- Биология
- Бухгалтерлік іс
- Валеология
- Ветеринария
- География
- Геология, Геофизика, Геодезия
- Дін
- Ет, сүт, шарап өнімдері
- Жалпы тарих
- Жер кадастрі, Жылжымайтын мүлік
- Журналистика
- Информатика
- Кеден ісі
- Маркетинг
- Математика, Геометрия
- Медицина
- Мемлекеттік басқару
- Менеджмент
- Мұнай, Газ
- Мұрағат ісі
- Мәдениеттану
- ОБЖ (Основы безопасности жизнедеятельности)
- Педагогика
- Полиграфия
- Психология
- Салық
- Саясаттану
- Сақтандыру
- Сертификаттау, стандарттау
- Социология, Демография
- Спорт
- Статистика
- Тілтану, Филология
- Тарихи тұлғалар
- Тау-кен ісі
- Транспорт
- Туризм
- Физика
- Философия
- Халықаралық қатынастар
- Химия
- Экология, Қоршаған ортаны қорғау
- Экономика
- Экономикалық география
- Электротехника
- Қазақстан тарихы
- Қаржы
- Құрылыс
- Құқық, Криминалистика
- Әдебиет
- Өнер, музыка
- Өнеркәсіп, Өндіріс
Қазақ тілінде жазылған рефераттар, курстық жұмыстар, дипломдық жұмыстар бойынша біздің қор #1 болып табылады.



Ақпарат
Қосымша
Email: info@stud.kz